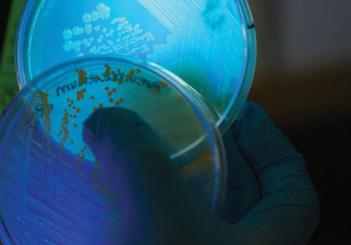

Annual Report 2025
Welcome
Dear Friends of the Auster Center,
What a blast to see the Auster Center for Applied Innovation and Research off to such a strong start in its first year. We are beginning to build a place where faculty, students, industry partners, and community members work side by side to turn research into real‑world impact. In a time when technology touches almost everything and our systems grow ever more complex, it has never been more important to bring together people from different disciplines and from the communities most affected by change, and to listen closely to them. The answers we need will come from many minds— people who might not otherwise meet—working together with curiosity, humility, and deep empathy for those we aim to serve.
We are still at the beginning, and we are profoundly grateful to the pioneers who stepped in during this first year to launch projects, test ideas, and support the Center. If you share this sense of possibility, we invite you to join us—as an active participant in our work, as a financial supporter, or both—so that together we can widen the Center’s reach and ambition. Onward and upward, from all of us at the Auster Center for Applied Innovation and Research.
With deep appreciation,
Filip Čučkov, PhD Director, Auster Center for Applied Innovation and Research

Kevin Oye
Executive Director, Tufts Gordon Institute


Catalyzing Broader Impact by Translating Research into Innovation
We support Tufts researchers in translating research into innovation through transdisciplinary collaboration, applied research partnerships, training programs, and student engagement.
Our Mission
To advance understanding of how innovation—particularly technology innovation and innovations touched by technology—can be fostered, translated, and applied to do good in the world.
We promote innovation in solving complex societal challenges through transdisciplinary approaches spanning social sciences, natural sciences, and technology for the public good.
Our Vision
To be a beacon for forward looking applied innovation and research pioneers, helping them navigate the complex challenges of the future through transdisciplinary collaboration and translating innovation into global impact for the benefit of all.
Our Story
In 2023, a $4 million gift from Charles “Chuck” Auster (A’73) brought that vision to life. Chuck Auster, Chairman of the Board of Advisors at the Derby Entrepreneurship Center (DEC), had seen firsthand what Tufts researchers were capable of. He also knew what was missing—a dedicated center to help them translate that capability into impact.
The Auster Center sits within the Tufts Gordon Institute (TGI) ecosystem alongside the Derby Entrepreneurship Center—DEC developing an entrepreneurial mindset and skill set, and Auster Center providing applied research capabilities and translation support.
Advancing Applied Innovation and Research at Tufts
The Auster Center helps Tufts researchers translate discoveries into real-world impact through transdisciplinary collaboration, systematic methodologies, and strategic partnerships.

Foster Innovation Communities
We build connections among researchers tackling complex challenges through workshops, seminars, policy influence, and engagement in the global ecosystem.

Develop Student Talent
We provide research opportunities through summer projects, undergraduate and graduate assistantships, and hands on applied innovation experience.

Build Research Capacity
We support faculty through the Fellows Program, innovation grants, customer discovery training, and grant collaboration.

Create Strategic Partnerships
We facilitate connections with industry, government agencies, academic institutions, and global innovation centers.
How We Work

Transdisciplinary Collaboration
Complex challenges rarely fit within a single field. We foster collaboration across disciplines, connecting complementary expertise that individual researchers find difficult to develop on their own.
INVESTED IN APPLIED RESEARCH AND INNOVATION GRANTS $50k
Evidence-Based & Systematic
Our methodologies align with how researchers think: form hypotheses, gather evidence, analyze findings, apply, and iterate based on data. We apply the scientific method to translate research.
INVESTED IN UNDERGRADUATE AND GRADUATE RESEARCH FELLOWSHIPS $34k

Customized Innovation Pathways
Some researchers explore applications and return to basic research. Others pursue partnerships or licensing. A few launch companies. We support all innovation pathways and respect researcher’s priorities.
57
NSF I-CORPS EVENTS ADVANCING RESEARCH TO COMMERCIALIZATION
16
8 RESEARCH TEAMS TRAINED IN NEW ENGLAND REGIONAL AND NATIONAL I-CORPS
UNDERGRADUATE AND GRADUATE RESEARCH FELLOWSHIPS IN APPLIED INNOVATION AND RESEARCH
5
INNOVATION PROGRAMS THAT CONNECT TUFTS RESEARCH TO REAL-WORLD APPLICATIONS AND IMPACT
Fellows Program
Investing in researchers who are dedicated to solving complex societal challenges through a transdisciplinary approach.
The research Fellows Program is designed to enhance Tufts University’s capacity for transdisciplinary research and innovation, and to promote a diverse community of researchers who collaborate on applied innovation and research translation.

What Fellows Do
Fellows are active builders of the Auster Center’s research community—developing transdisciplinary research networks, engaging in cross disciplinary collaboration, building industry and academic partnerships, and mentoring the next generation of researchers and inventors to advance state of the art knowledge in applied innovation.

Who Are Our Fellows
Auster Center Fellows advance our understanding of how innovation can be fostered, translated, and applied to do good in the world. Open to Tufts researchers from every school and discipline, Fellows direct a program in their area of expertise—supported by a peer network, expert guidance, and funding.
Innovation Programs
Each
Fellow
directs an innovation program in an area of their expertise:
• Civic Innovation
• Social Innovation
• Innovation in Advancing Democracy
• Educational Innovation
• Medical Innovation
• Medical Technologies Innovation
• Regenerative Medicine Innovation
• Brain Health Innovation
• Innovation in Improving Health Outcomes
• Innovation in Infection and Immunity
• Innovation in Aging
• Agricultural Innovation
• Cellular Agriculture Innovation
• Food and Nutrition Innovation
• Corporate Innovation
• Spotlight on the Civic Innovation Program
• Financial Innovation
• Defense Innovation
• Cybersecurity Innovation
• Energy Innovation
• Environmental Innovation
• Sustainability Innovation
• Materials Innovation
• Artificial Intelligence Innovation
• Robotics Innovation
The Civic Innovation Program, directed by the center’s inaugural Fellow, Dr. Jonathan Garlick, a Tufts faculty member and Founding Director of the Civic Science Collective, focuses on Trust in Artificial Intelligence (AI).
This program prioritizes inclusivity and ensures the representation of diverse perspectives,identities, beliefs, and experiences. It aims to support the translation of research ideas into new and improved approaches to addressing community issues and enhancing citizens’ lives, with attention to the social dimensions of AI. The program’s focus is to advance priorities for the Civic Innovation Seed Grant initiative by deepening our understanding of the concerns, hopes, challenges, and opportunities individuals and communities face regarding Trust in AI.
Jonathan Garlick, DDS, PhD
Fellow and Director of the Civic Innovation Program
Jonathan Garlick is Professor at Tufts University’s School of Dental Medicine, School of Medicine, School of Engineering and the Graduate School of Biomedical Sciences. His NIH funded research laboratory pioneers the use of stem cells in tissue engineering to develop new treatments for cancer, scleroderma, and diabetes related complications. He founded and leads the Civic Science Collective, a national initiative working to support scientists and citizens with the knowledge, skills and practices needed to promote a culture of science that includes all who seek to participate. His Dialogue Center at the Civic Science Collective is a place where people can talk about and better understand the values and world views of others on controversial and complex science and health related issues with societal dimensions. As an educator, Jonathan teaches students, scientists and citizens to explore the impact of science in their lives, so they can earn public trust and strengthen civic life.

Innovate2Impact
Where Medical Research Meets Market Reality
Innovate2Impact is a joint program between the Auster Center and the Tufts Clinical & Translational Science Institute (CTSI) that helps researchers bring health innovations from the lab to market.
When researchers at Tufts Medical School develop breakthrough health innovations, they face a common challenge: How do you move from laboratory success to patient impact?
That’s why the Clinical & Translational Science Institute partnered with the Auster Center for Applied Innovation and Research to create Innovate2Impact—a program that connects medical researchers with the commercialization expertise, industry networks, and funding needed to bring health innovations to market.
CTSI brought clinical and translational research expertise from Tufts Medical School. The Auster Center contributed technology commercialization expertise, NSF I-Corps training, and connections to industry partners and investors. Together, we built a complete pathway from early concept to funded venture.
The program launched with an Innovation Expo, where researchers showcased innovations and received feedback from industry experts and clinical specialists. The Expo drew 108 attendees from 40 Massachusetts organizations, underscoring broad interest across academia, healthcare, industry, and the innovation ecosystem. Finalists received mentorship and an invitation to compete for up to $50K at the Impact Launchpad, a pitch event for early stage health innovations with growth potential.
The Impact Launchpad offers an early look at emerging ideas and opportunities for investment, collaboration, and partnerships in a dynamic setting and is co sponsored by Tufts, Northeastern, MIT, and supported by statewide engagement.
tuftsctsi.org/innovate2impact


NSF Innovation Corps
Advancing Innovation to the National Stage
The National Science Foundation Innovation Corps (NSF I-Corps) program prepares university researchers to evaluate the commercial potential of their innovations.
In 2025, Tufts University became a founding member of the NSF I-Corps New England Hub—an eight university consortium funded by the National Science Foundation to accelerate the translation and commercialization of federally funded research into societal impact, whether through launching startups, licensing technologies, or open sourcing the research. Being part of the Hub extends the Auster Center’s reach across the New England Region.
This year alone, the Auster Center trained 14 teams, comprising 30 individuals, through the New England regional program, with 2 teams advancing to the highly selective National NSF I Corps program, receiving $100k in support of translating their research.
neicorps.org
Kofimi Technology, Inc. From Lab to National Stage
Dr. Valencia Koomson, Professor, Electrical and Computer Engineering, founded Kofimi to launch a new bias free pulse oximeter medical device. Through TGI’s integrated ecosystem, the venture won the prestigious Stephen and Geraldine Ricci Interdisciplinary Prize at the Derby Entrepreneurship Center’s Tufts New Ventures Competition.

With this momentum, Kofimi advanced to the National NSF I-Corps program, where Professor Koomson and her team conducted intensive customer discovery and refined their commercialization strategy. The venture exemplifies how TGI, via the Derby and Auster Centers, supports innovation across the entire university— from student startups to faculty‑led research.
kofimi.com

Where Research Powers Reality
The work doesn’t end when the research is done.
We specialize in the vital final step: facilitating strategic partnerships between researchers and the organizations that need their expertise. Together, we create value that reaches far beyond the lab.
Entegris, Inc.
Turning Unused Data Into Development Insights
Entegris, a leading supplier of advanced materials and process solutions for the semiconductor and life sciences industries, needed to transform unused experimental data into actionable insights for new product development.
The Auster Center brought together the essential elements: Entegris engineers who understood their experimental designs, faculty research leadership from Abani Patra, Director of the Tufts Data Intensive Studies Center, and graduate students working hands on with industrial scale data.
The result created value for everyone. Entegris turned collected data into a strategic asset for their global product development process. The Tufts Data Intensive Studies Center gained direct insight into semiconductor industry challenges. And students gained hands on experience at a global company—the kind of project that leads to internships and careers.
entegris.com

In Her Shoes, Inc. Innovation in Support of Food Security
Smit Patel, inaugural Auster-Tisch Summer Fellow and recent M.S. in Engineering Management graduate, spent the summer of 2025 working with In Her Shoes—a nonprofit tackling food insecurity and reducing food deserts in the Mississippi Delta through mobile food trucks and community engagement.
Smit applied his project management, financial modeling, and strategic planning skills across four areas: a financial sustainability model for the mobile truck program, a corporate presentation for Walmart, customer survey development, and a full website redesign—empowering an underserved community through innovation.
“These lessons will carry forward into my future career, equipping me with the ability to design solutions that are not only innovative but also sustainable and community focused,” said Smit about his research fellowship experience.
inhershoesinc.org
Empower discovery. Join our journey.

The Auster Center aims to bridge the gap between Tufts University’s research and its real-world impact.
Every innovation program we implement, partnership we establish, and Fellow we support brings us closer to our goal. None of this is possible without people who have faith in what can be achieved.
If you see yourself in these pages—whether it’s the researchers sharing their work with the world, the students gaining valuable experience to kick start their careers, innovation programs pushing the boundaries of applied science, or the partners discovering solutions they couldn’t find on their own—know that there’s a place for you on this journey.
Connect With Us
AusterCenter@Tufts.edu
AusterCenter.Tufts.edu
LinkedIn.com/company/AusterCenter
Instagram.com/AusterCenter
Support Our Mission Support an Innovation Program
Innovation program seed grants give researchers the runway to explore real world applications of their work. Your support funds that critical next step.
Endow a Fellow
Fellows are the heart of our research community. Endowing a Fellowship puts your name behind the researchers translating discovery into impact.
Sponsor a Partnership
Industry sponsored research creates value for companies, faculty, and students alike. Connect your organization to Tufts research talent.
Make a Gift
Every contribution supports the programs, training, and community that help Tufts researchers do more with their discoveries.